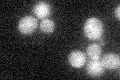
YJL191W
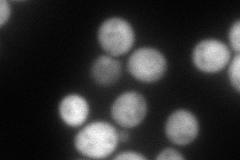
YJL191W
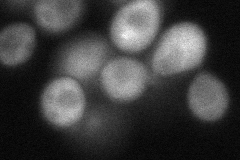
YJL191W
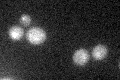
YJL191W
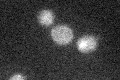
YJL191W

View description
Ribosomal protein 59 of the small subunit, required for ribosome assembly and 20S pre-rRNA processing; mutations confer cryptopleurine resistance; nearly identical to Rps14Ap and similar to E. coli S11 and rat S14 ribosomal proteins
Localization:
Intensity:
Fold change:
Significance:
-
C’ GFP library in SD
below threshold16.28 -
N' NOP1pr-GFP in SD

cytosol120.522 -
N' TEF2pr-mCherry in SD
cytosol115.686 -
N' NATIVEpr-GFP in SD

cytosol412.711 -
N' TEF2pr-VC and Cyto-VN in SD
cytosol59.8815 -
C’ GFP library in SD+DTT
cytosol17.261.05No -
C’ GFP library in SD+H2O2
cytosol17.461.07No -
C’ GFP library in Starvation Media

cytosol15.930.97No -
C’ GFP library on the background of Pup2-DaMP

below threshold -
C’ GFP library on the background of CCT mutant

below threshold17.96891.10322No
